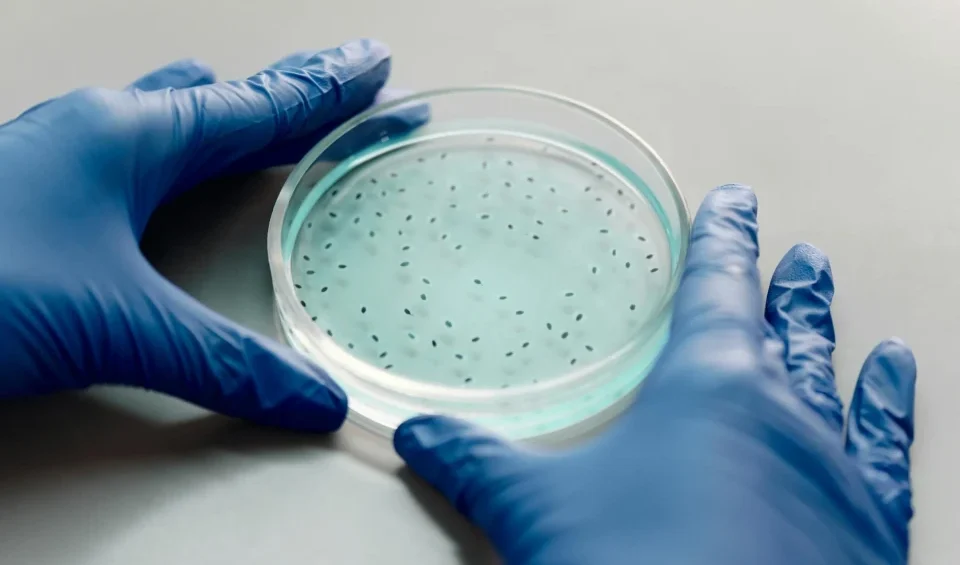
Autophagy and Spirulina

Aging is an inevitable biological process, accompanied by various structural and functional changes in the human body. With age, cells accumulate damage, their ability to regenerate decreases, which can lead to a variety of chronic diseases – from cardiovascular diseases to neurodegenerative disorders such as Alzheimer’s and Parkinson’s disease. As a result, there is increasing […]
CategoriesScience
CategoriesScience